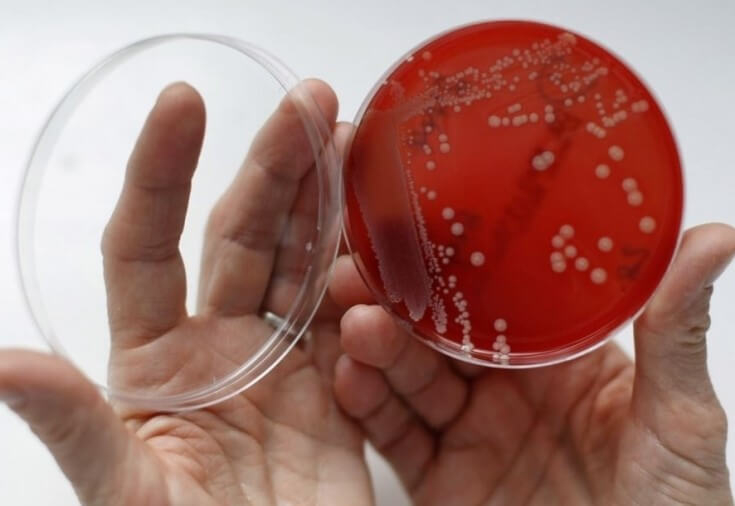
Бактериальный вагиноз: современные данные относительно причин заболевания

Відомо, що серед інфекційних захворювань сечостатевої системи у жінок, зокрема фертильного віку, найпоширенішим сьогодні є бактеріальний вагіноз (БВ).
Бактеріальний вагіноз − інфекційний синдром, пов'язаний з дисбіозом піхви, який характеризується високою концентрацією облігатних анаеробних мікроорганізмів та різким зниженням вмісту лактобацил або їх відсутністю.
Дізнайтеся у статті на estet-portal.com про основні підходи до діагностики та лікування бактеріального вагінозу.
- Мікроорганізми, які відіграють роль у розвитку бактеріального вагінозу
- Розвиток патологічного процесу при бактеріальному вагінозі
- Бактеріальний вагіноз у статевих партнерів
Мікроорганізми, які відіграють роль у розвитку бактеріального вагінозу
Бактеріальний вагіноз є незапальним захворюванням, проте здатним значно обтяжувати перебіг ІПСШ.
На сьогодні визначено вже понад 40 мікробних агентів, які відіграють роль у розвитку бактеріального вагінозу.
Читайте нас у Instagram!
Серед них найбільше значення мають:
- Gardnerella vaginalis;
- Mycoplasma hominis;
- Mycoplasma genitalium;
- Ureaplasma urealiticum;
- Bacteroides;
- Prevotella;
- Porphyromonas;
- Peptostreptococcus;
- Fusobacterium nuclearum;
- Enterococcus;
- Candida spp.;
- Listeria monocytogenes;
- Mobiluncus;
- Leptotrichia;
- Streptococcus viridens та ін.
Що необхідно враховувати при призначенні замісної гормональної терапії?
Виражена запальна реакція з боку вагінального епітелію при бактеріальному вагінозі зазвичай відсутня.
Масивне розростання змішаної флори пов'язане із втратою «нормальних» Lactobacillus spp.
Завдяки розвитку лабораторних методів діагностики, зокрема методу ампліфікації нуклеїнових кислот з виявленням мікроорганізмів, які важко культивуються, констатовано високу частоту виявлення при бактеріальному вагінозі Atopobium vaginae (A. vaginae) (77-96%) на 77-96%. -79%).
Але при рецидивному бактеріальному вагінозі A. vaginae виявлена в 75%, а G. vaginalis − у 100% випадків, що дозволяє говорити про безперечно велику відповідальність останньої за рецидивування захворювання.
Уточнено особливість, яка полягає в тому, що A. vaginae майже ніколи не буває моноінфекцією, без супроводу G. vaginalis.
При асоціації цих збудників рецидивуючий бактеріальний вагіноз діагностують у 83% пацієнтівок.

Розвиток патологічного процесу при бактеріальному вагінозі
Основними причинами розвитку патологічного процесу у піхві слід вважати:
- ендокринні розлади;
- зміна стану місцевого імунітету (зниження імуноглобуліну А, циркулюючих імунних комплексів, С3-компонента комплементу, підвищення імуноглобуліну G);
- безсистемну антибактеріальну терапію;
- перенесені або супутні запальні захворювання жіночих статевих органів;
- застосування контрацептивів (пероральних, внутрішньоматкових, сперміцидів);
- хірургічні та діагностичні втручання.
Гінекологічні інфекції. Новий підхід у лікуванні трихомоніазу
У жінок зі скаргами на тривалі, резистентні до лікування патологічні виділення, бактеріальний вагіноз діагностували у 95% випадків.
Після впровадження в лабораторно-діагностичну практику наборів реагентів, що дозволяють виявляти анаеробну та мікроаерогенну мікрофлору (за допомогою методу ПЛР), стало відомо, що наведені мікроорганізми можуть викликати дисбактеріози сечостатевої системи також і у чоловіків.
Подібні стани були описані відносно нещодавно, і тому вони ще не мають загальновизнаного назвиия.

Бактеріальний вагіноз у статевих партнерів
Вивчення протозойних інвазій сечостатевої системи, що протікають у поєднанні з ураженнями, викликаними мікроорганізмами, які асоційовані з бактеріальним вагінозом, у жінок фертильного віку та їх статевих партнерів-чоловіків є перспективним напрямом сучасної медицини, розвиток якого може сприяти значному підвищенню рівня діагностичного з ІПСШ і, як наслідок, підвищення ефективності їх лікування.
Насамперед за рахунок обґрунтування проведення специфічної антибактеріальної терапії відповідним хворим, а також заходів щодо запобігання їх реінфікуванню.
Терапія вульвовагінальної атрофії СО2-лазером
Для успішного лікування бактеріального вагінозу доцільно робити індивідуальну етіологічну діагностику складових цього захворювання з метою виявлення саме тих його факторів, які мають підлягати медикаментозній корекції.
Причому важливо, щоб відповідна діагностика була не лише якісною, а й кількісною, оскільки визначити, які саме складові цієї поліетиологічної патології є збудниками захворювання та підлягають корекції, можна лише за їх співвідношенням до показника загальної бактеріальної маси у зразку досліджуваного.
Ановуляторний цикл: тимчасове явище або причина безпліддя
Для етіотропного лікування бактеріального вагінозу сьогодні застосовують антибіотики груп нітроімідазолів та фторхінолонів.
Саме речовини цих хімічних груп мають здатність впливати на більшість із збудників бактеріального вагінозу.
Тому поєднання саме нітроімідазолів та фторхінолонів найчастіше використовують при емпіричному доборі специфічної терапії при БВ.

Додати коментар